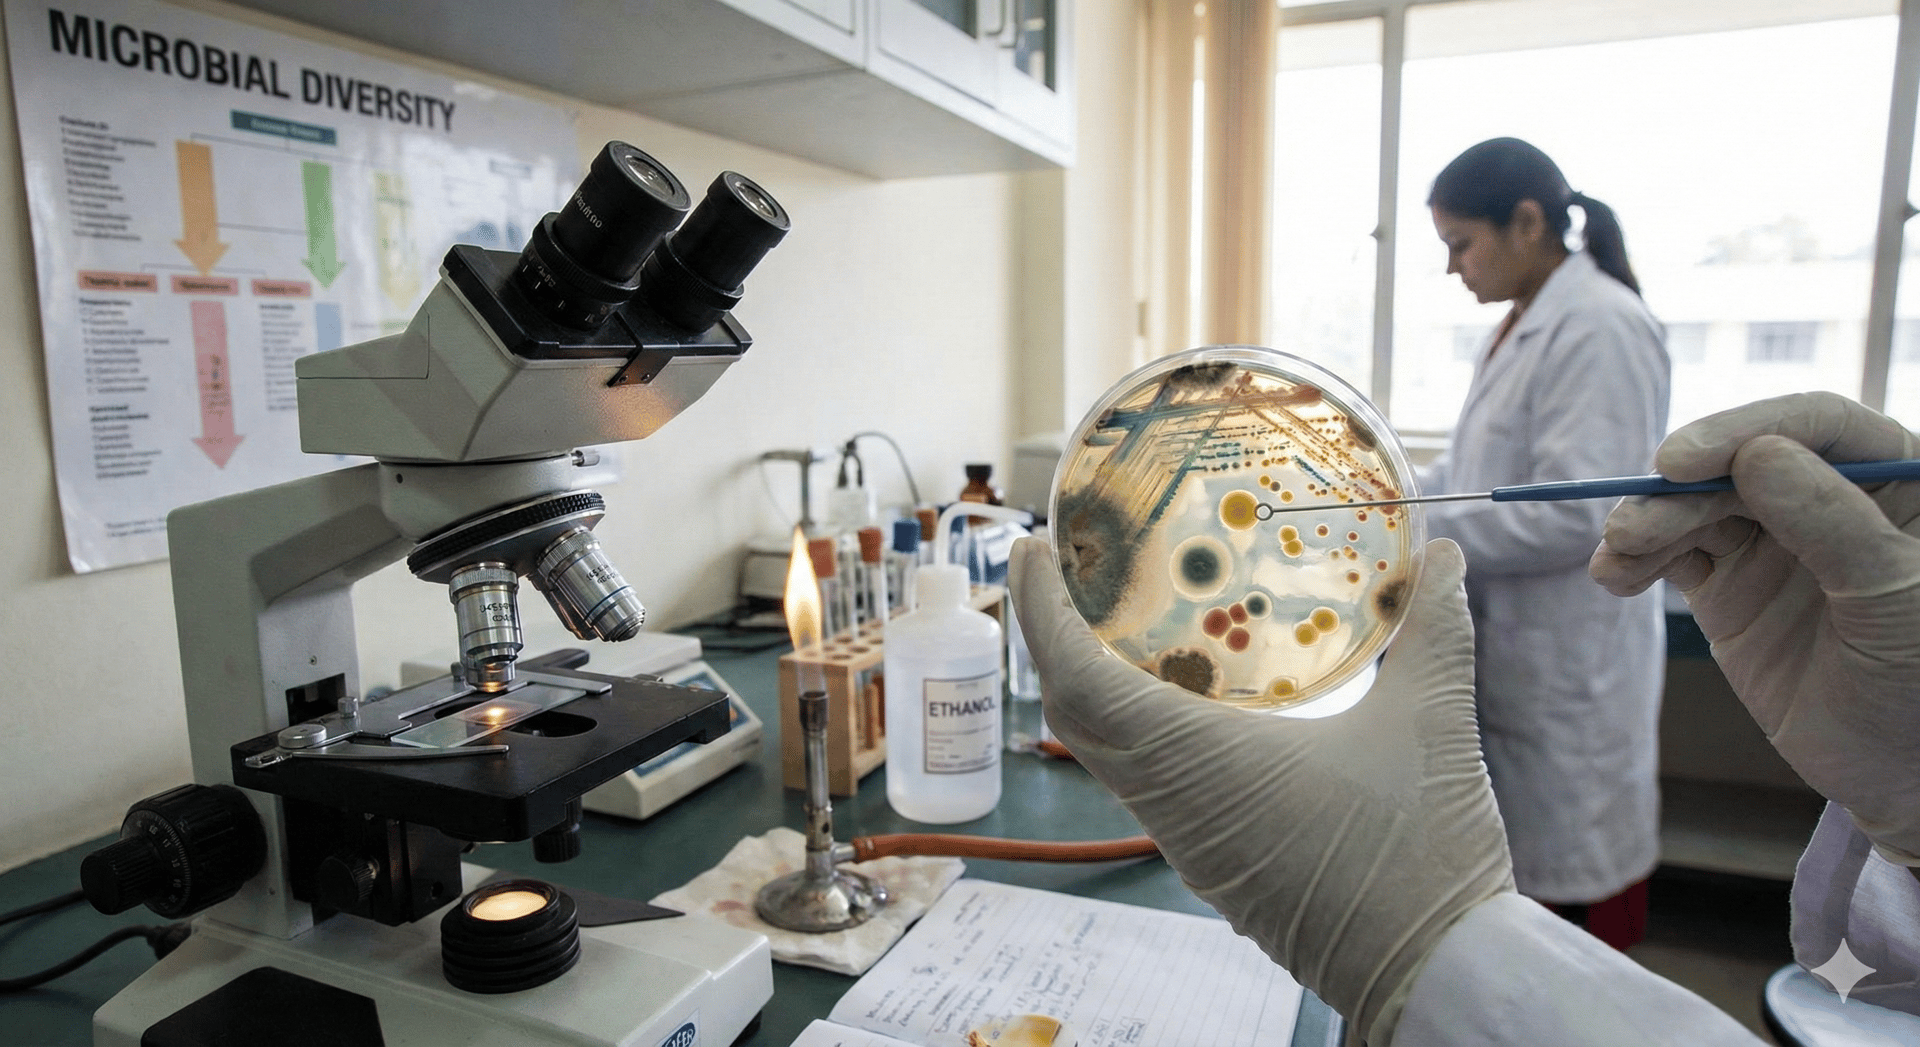

NUESTRO
EQUIPO
"Tu salud es nuestra prioridad. Conoce al equipo de expertos dedicados a cuidarte."
/ Equipo /
Nuestra Gente:
Equipo ético y calificado
Nuestro equipo comprometido con tu salud.


Md. Lizbeth Cardenas S.
Médico General


Gabriela Medina F.
Auxiliar de laboratorio


Dra. Inés Suárez I.
Bioquímica Farmacéutica




Valeria Lozado
Auxiliar de laboratorio
Norma Vázquez T.
Lcda. en laboratorio clínico


Calidad
Garantizamos resultados precisos y confiables.


Eficiencia
Procesos rápidos sin perder exactitud.




Confianza
Atención cercana y responsable siempre.
Innovación
Tecnología que impulsa nuestro trabajo.
/ Proyectos /
Nuestros proyectos
Rigor Científico y compromiso social
"Cada proyecto refleja nuestra capacidad técnica y nuestros valores éticos."
/ Nosotros /
Somos seguridad y confianza
en resultados










Tecnología de punta
La más avanzada y prominente tecnología en el campo.
Personal
Profesional y altamente capacitado.
Normas
Nos regimos a normas y estándares internacionales.


